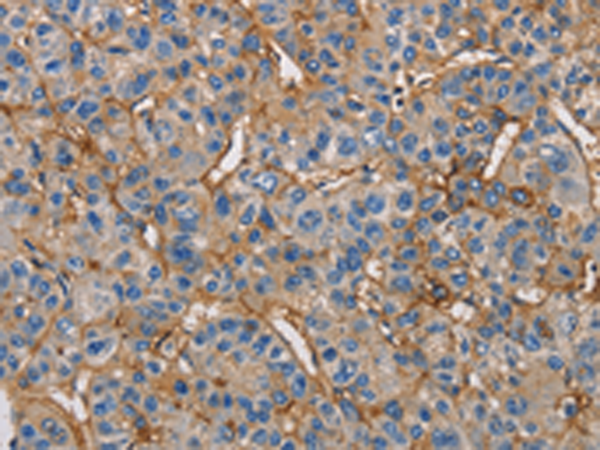
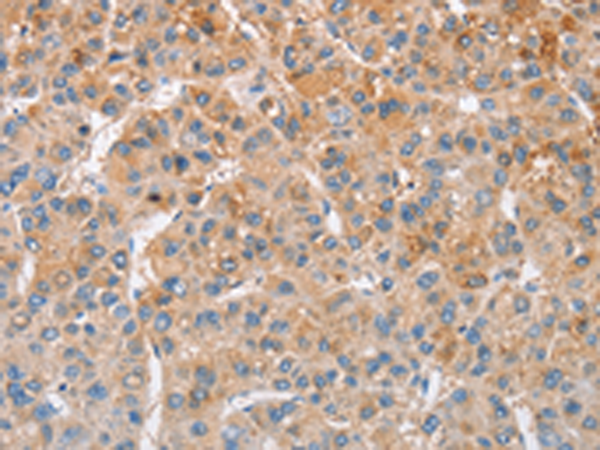
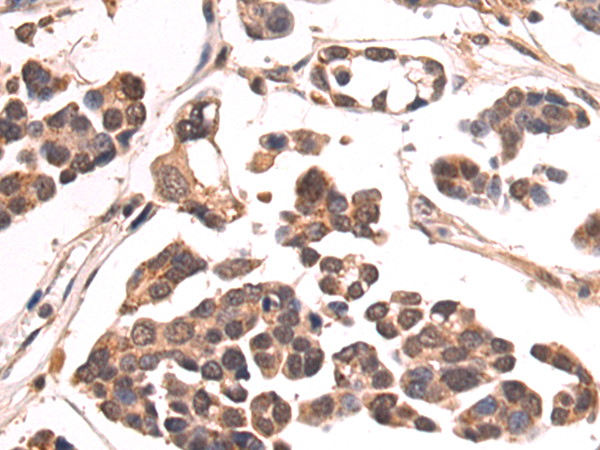
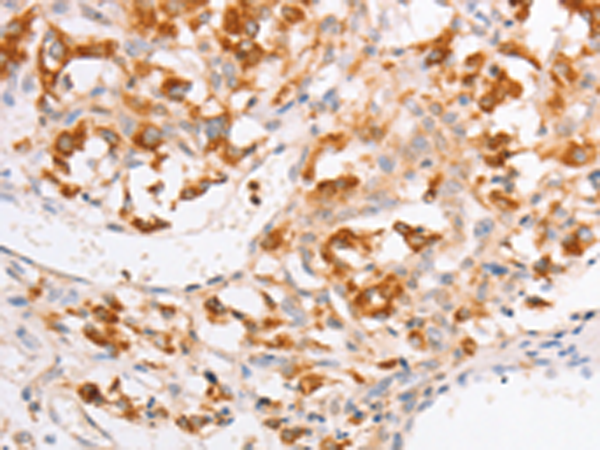
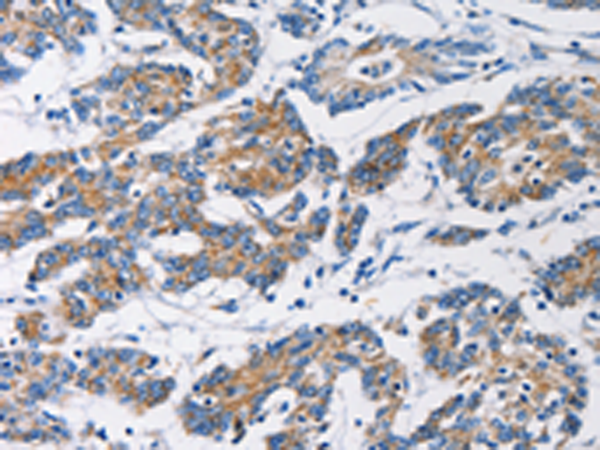

-
分类: 科研抗体货号: P07973别名: PIM应用: IHC反应种属: Human, Mouse, Rat
-
分类: 科研抗体货号: P07991别名: BB2; CD54; P3.58应用: WB,IHC反应种属: Human
-
分类: 科研抗体货号: P08010别名: ZFYVE11; FYVE-DSP2应用: IHC反应种属: Human, Mouse
-
分类: 科研抗体货号: P07972别名: SHIK; SgK495应用: IHC反应种属: Human, Mouse, Rat
-
分类: 科研抗体货号: P07990别名: KLC; KNS2; KNS2A应用: WB,IHC反应种属: Human, Mouse, Rat
-
分类: 科研抗体货号: P08006别名: UCHL2; hucep-6; HUCEP-13应用: WB,IHC反应种属: Human, Mouse, Rat
-
分类: 科研抗体货号: P07971别名: TYRRS; CGI-04; MLASA2; MT-TYRRS应用: WB,IHC反应种属: Human, Mouse, Rat
-
分类: 科研抗体货号: P07989别名: FAK; FADK; FAK1; FRNK; PPP1R71; p125FAK; pp125FAK应用: WB反应种属: Human, Mouse, Rat
-
分类: 科研抗体货号: P08005别名: NT; eN; NT5; NTE; eNT; CD73; E5NT; CALJA应用: IHC反应种属: Human, Mouse, Rat
-
分类: 科研抗体货号: P07987别名: HKD; HKI; HXK1; HMSNR; HK1-ta; HK1-tb; HK1-tc应用: WB,IHC反应种属: Human, Mouse, Rat

鄂公网安备42018502007531号
鄂公网安备42018502007531号

